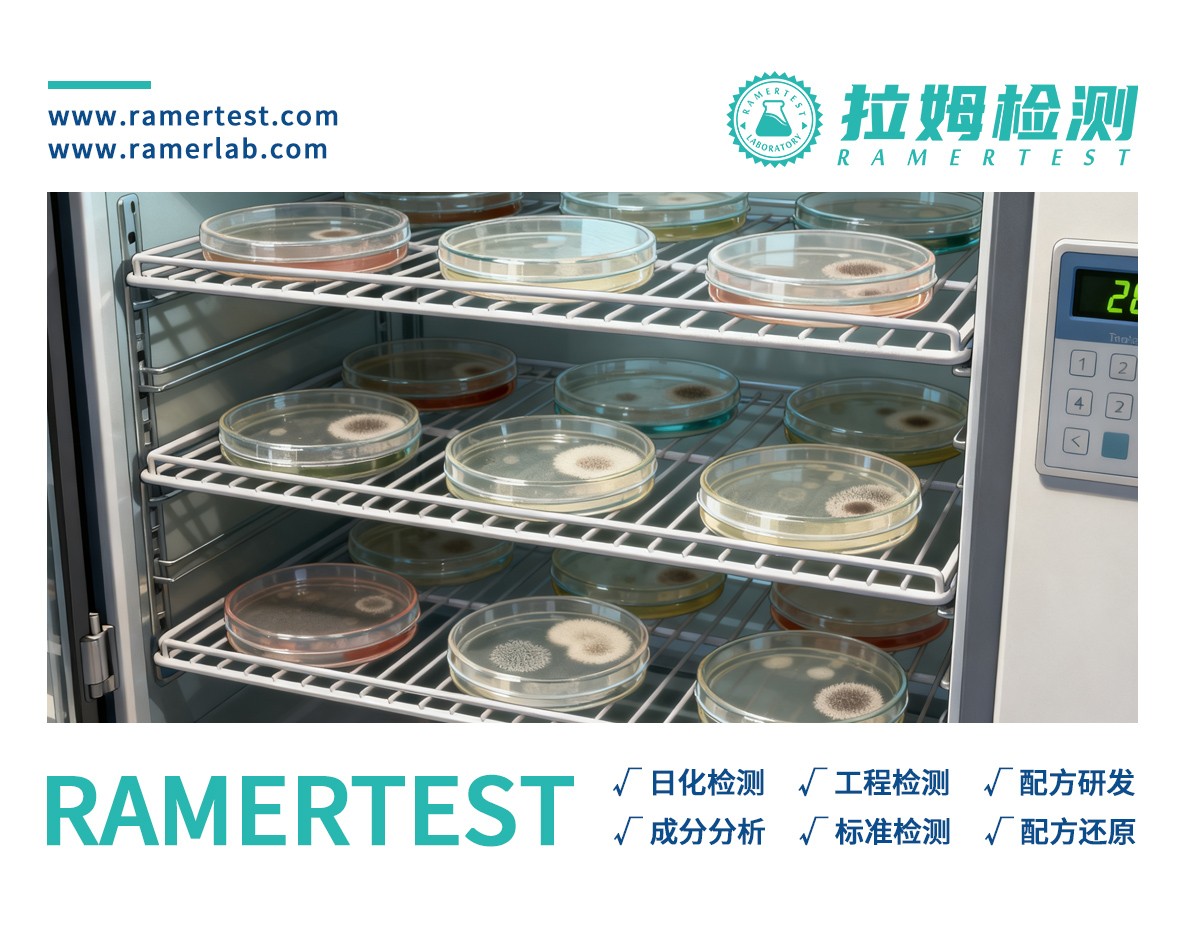

你用的化妆品,可能藏着“看不见的杀手”?微生物检测才是安全底线
来源:本站 发布时间:2025年09月30日
拉姆化妆品联合实验室——你用的化妆品,可能藏着“看不见的杀手”?微生物检测才是安全底线
Ram Cosmetics Joint Laboratory - The cosmetics you use may harbor "invisible killers"—microbial testing is the safety baseline
你有没有过这样的经历:新买的精华液用了没几天,脸上突然冒出红肿的小疙瘩;或者开封已久的面霜,瓶底悄悄浮起一层细密的“小绒毛”?别以为这只是“产品变质”那么简单——背后可能藏着化妆品微生物超标的隐患。
对于爱美之人来说,化妆品是日常护肤、美妆的“刚需品”,但很少有人知道:我们每天涂抹在脸上的乳液、精华、口红,其实是微生物的“天然温床”。今天就来和大家聊聊,守护化妆品安全的关键环节——微生物检测,看看它如何帮我们挡住那些“看不见的威胁”。

拉姆检测化妆品联合实验室,欢迎来电咨询:4006160084
为什么化妆品会“招”微生物?
首先要搞懂一个问题:微生物明明看不见摸不着,怎么会跑到化妆品里?其实答案就藏在化妆品的成分和使用过程中。
化妆品里的水分、油脂、氨基酸、维生素等成分,对我们的皮肤是“营养剂”,对微生物来说更是“美味佳肴”。比如爽肤水的含水量通常超过80%,乳液里的天然油脂(如乳木果油、橄榄油),这些都能让细菌、霉菌快速繁殖。
更易被忽视的是“人为污染”:每次用手挖取面霜时,手上的汗液、细菌会直接接触产品;开封后长时间暴露在空气中,灰尘里的微生物会“趁虚而入”;甚至有些消费者习惯把化妆品放在浴室——潮湿、温暖的环境,简直是微生物的“繁殖乐园”。
一旦微生物数量超标,不仅会让化妆品变质(比如出现异味、分层、长毛),更可怕的是会伤害皮肤:轻则引发红肿、瘙痒、粉刺,重则导致毛囊炎、湿疹,甚至眼部、口腔感染(比如口红被污染后可能引发唇炎)。而微生物检测,就是在这些“威胁”爆发前,把它们拦在货架之外。

微生物检测到底在“查”什么?
提到“检测”,很多人会以为是“随便看看有没有细菌”——但实际上,化妆品微生物检测有严格的国家标准,不是“走过场”。根据GB 7918-2013《化妆品安全技术规范》 ,所有上市化妆品都必须通过两项核心检测:“致病菌限量”和“霉菌酵母菌总数”,这是不可逾越的“安全红线”。
我们可以把检测对象分为3类“隐形杀手”,每一类都有明确的“死刑标准”:
1. 致病菌:0容忍,发现即不合格
致病菌是对皮肤危害最大的“元凶”,国标明确要求“不得检出”,哪怕只有1个也不行。最常见的有两种:
• 金黄色葡萄球菌:这是皮肤表面常见的“坏细菌”,一旦进入毛孔,会引发毛囊炎、脓疱疮,严重时还会导致皮肤溃烂。如果化妆品(尤其是面霜、粉底液)被它污染,涂抹后很容易诱发“闷痘”“红肿”。
• 铜绿假单胞菌(绿脓杆菌):它特别喜欢“躲”在含水化妆品里(比如化妆水、精华液),对黏膜的刺激性极强。如果不慎接触到眼睛(比如用污染的手涂眼霜),可能引发结膜炎、角膜炎,甚至导致视力下降。
除了这两种,婴幼儿化妆品还会额外检测“大肠杆菌”——因为婴幼儿皮肤更娇嫩,大肠杆菌可能引发尿布疹、皮肤感染,检测标准比成人化妆品更严格。
2. 霉菌酵母菌:总数不能“超标”
霉菌和酵母菌是导致化妆品“长毛”“变味”的主要原因,比如面霜里的白色絮状物、口红上的小黑点,大多是它们的“杰作”。
国标对这类微生物的要求是“总数控制”:普通化妆品(如乳液、爽肤水)每克/毫升不能超过100CFU(菌落形成单位,可理解为“微生物数量”);眼部化妆品、口唇化妆品(如眼影、口红)则更严格,每克/毫升不能超过50CFU。
别觉得“100CFU”很多——如果一瓶面霜的霉菌数量达到200CFU,开封后3天内就可能出现肉眼可见的“霉点”,此时涂抹在脸上,很容易引发过敏反应。
拉姆检测化妆品联合实验室,欢迎来电咨询:4006160084
一瓶化妆品的“安全考试”:检测流程有多严?
微生物检测不是“取点样品随便测”,而是一套从取样到判定的“全链条把关”流程。我们可以把它想象成检测员给化妆品“开小灶”——先“引诱”微生物现身,再判断它是否“超标”。
第一步:取样——精准“抓线索”
检测员会按照“无菌操作”原则取样:比如检测面霜时,会用无菌勺子从瓶身中部、底部各取一勺(避免只取表面样品,漏过底部可能滋生的微生物);检测化妆水时,会用无菌吸管抽取中层液体(防止瓶口污染影响结果)。
关键是“代表性”——如果是批量产品,会从不同批次、不同包装里随机取样,确保结果能反映整批产品的情况,避免“个别合格,多数超标”的漏洞。
第二步:培养——让微生物“现原形”
取样后,检测员会把样品放进“特制培养基”里——这相当于给微生物“准备营养丰富的大餐”,再放进37℃的恒温箱(模拟人体皮肤温度),让微生物快速繁殖。
比如检测金黄色葡萄球菌时,会用“甘露醇高盐培养基”——这种培养基里的高盐环境,能抑制其他杂菌生长,只让金黄色葡萄球菌“冒头”;检测霉菌时,则会用“孟加拉红培养基”,霉菌长出来后会呈现红色菌落,一目了然。
通常培养时间需要24-72小时:细菌24小时就能长出菌落,霉菌则需要3-5天。如果培养基里没有长出菌落,说明“未检出致病菌”;如果长出了菌落,就需要进一步鉴定它的种类和数量。
第三步:计数与判定——划“安全线”
培养结束后,检测员会用“菌落计数器”统计菌落数量:如果每克样品里的致病菌菌落数为0,霉菌酵母菌总数低于国标限值,说明产品“合格”;反之则判定为“不合格”,这批产品会被禁止上市,甚至召回销毁。
更严格的是“复检”——如果第一次检测发现疑似超标,会重新取样、重新培养,避免因操作失误导致误判。毕竟,每一瓶不合格的化妆品,都可能威胁到消费者的皮肤安全,容不得半点马虎。

拉姆检测化妆品联合实验室,欢迎来电咨询:4006160084
消费者怎么避开“微生物超标”的坑?
了解了微生物检测的重要性,我们在买化妆品、用化妆品时,也能掌握一些“自保技巧”,减少风险:
1. 看“来源”:选正规品牌,拒绝“三无产品”
正规品牌会在包装上标注“执行标准GB 7918”,部分产品还会附带“检测报告”(比如线上店铺的详情页、线下专柜的备案文件)。而“三无产品”(无生产日期、无质量合格证、无生产厂家)大多没有经过微生物检测,风险极高,千万别买。
2. 看“性状”:变质的化妆品别再用
如果化妆品出现这些情况,哪怕没到保质期,也可能是微生物超标了:① 出现异味(比如酸味、霉味);② 质地变化(比如乳液分层、精华变浑浊、面霜结块);③ 出现异物(比如黑点、绒毛、小颗粒)。此时一定要立即停用,避免伤害皮肤。
3. 用“方法”:减少人为污染
• 尽量选“按压式包装”的化妆品(比如按压瓶精华),避免用手直接接触;
• 用手挖取面霜时,先洗手,或者用无菌棉签/小勺;
• 开封后的化妆品别放浴室,放在阴凉干燥处,且尽快在保质期内用完(比如面霜开封后建议3-6个月内用完)。
写在最后:微生物检测,是化妆品的“安全身份证”
对于化妆品来说,好看的包装、好闻的香味是“加分项”,而通过微生物检测、确保安全,则是“必答题”。毕竟,我们化妆、护肤的初衷是“变美”,不是“用皮肤冒险”。
微生物检测看似是“幕后工作”,却默默守护着每一位消费者的皮肤健康——它挡住了致病菌,拦住了变质产品,让我们能安心地涂抹面霜、画眼影、涂口红。
希望这篇文章能让你对化妆品安全多一份了解:下次再拿起一瓶化妆品时,你不仅能看到它的“颜值”,更能读懂它背后“看不见的安全防线”。也愿每个爱美的人,都能在安全的前提下,遇见更好的自己。



